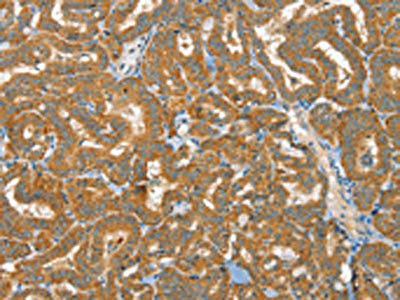

-
中文名稱:RAB25兔多克隆抗體
-
貨號:CSB-PA834031
-
規格:¥1100
-
圖片:
-
The image on the left is immunohistochemistry of paraffin-embedded Human thyroid cancer tissue using CSB-PA834031(RAB25 Antibody) at dilution 1/40, on the right is treated with fusion protein. (Original magnification: ×200)
-
The image on the left is immunohistochemistry of paraffin-embedded Human liver cancer tissue using CSB-PA834031(RAB25 Antibody) at dilution 1/40, on the right is treated with fusion protein. (Original magnification: ×200)
-
-
其他:
產品詳情
-
Uniprot No.:
-
基因名:RAB25
-
別名:CATX 8 antibody; CATX-8 antibody; CATX8 antibody; RAB11C antibody; RAB25 antibody; RAB25 member RAS oncogene family antibody; RAB25_HUMAN antibody; Ras related protein Rab 25 antibody; Ras-related protein Rab-25 antibody; RP11-336K24.10-001 antibody
-
宿主:Rabbit
-
反應種屬:Human,Mouse
-
免疫原:Fusion protein of Human RAB25
-
免疫原種屬:Homo sapiens (Human)
-
標記方式:Non-conjugated
-
抗體亞型:IgG
-
純化方式:Antigen affinity purification
-
濃度:It differs from different batches. Please contact us to confirm it.
-
保存緩沖液:-20°C, pH7.4 PBS, 0.05% NaN3, 40% Glycerol
-
產品提供形式:Liquid
-
應用范圍:ELISA,IHC
-
推薦稀釋比:
Application Recommended Dilution ELISA 1:2000-1:5000 IHC 1:40-1:150 -
Protocols:
-
儲存條件:Upon receipt, store at -20°C or -80°C. Avoid repeated freeze.
-
貨期:Basically, we can dispatch the products out in 1-3 working days after receiving your orders. Delivery time maybe differs from different purchasing way or location, please kindly consult your local distributors for specific delivery time.
-
用途:For Research Use Only. Not for use in diagnostic or therapeutic procedures.
相關產品
靶點詳情
-
功能:Involved in the regulation of cell survival. Promotes invasive migration of cells in which it functions to localize and maintain integrin alpha-V/beta-1 at the tips of extending pseudopodia. Involved in the regulation of epithelial morphogenesis through the control of CLDN4 expression and localization at tight junctions. May selectively regulate the apical recycling pathway. Together with MYO5B regulates transcytosis.
-
基因功能參考文獻:
- ZEB2 directly binds to E-box sequences in the RAB25 promoter.ZEB2 stably represses RAB25 expression through epigenetic regulation by SIRT1 during epithelial-to-mesenchymal transition. PMID: 30445998
- Results indicated that miR-577 suppressed EMT by inhibiting Rab25 expression in breast cancer (BC). MiR-577 and Rab25 are considered potential targets of BC treatment. PMID: 29524309
- Rab25 is amplified and enhances aggressiveness in luminal B cancers while in claudin-low tumors, Rab25 is lost indicating possible anti-tumor functions PMID: 27259233
- Our results suggest that Rab25 tumourigenic potential and chemoresistance relies on HIF1 activity in aggressive and metastatic ovarian cancer PMID: 26967059
- The results from this analysis indicated that Rab11a, Rab11c(Rab25) and Rab14 were expressed in a wide range of cell lines, including the human placental trophoblastic BeWo cell line. PMID: 28922401
- Data show that Rab25 is responsible for RIN1-induced EGFR signaling and tumor malignancy in clear cell renal cell carcinoma cell. PMID: 28612496
- Promoter methylation results in downregulation of RAB25 expression in oropharyngeal squamous cell carcinoma. Decreased Rsb25 expression is associated with lymph node metastasis. PMID: 27379752
- Rab25 may act as a tumor promoter. PMID: 28281975
- Rab25 was upregulated in hepatocellular carcinoma tissues and cells compared with normal liver tissues and cell lines. Rab25 overexpression correlated with advanced tumor stage and nodal metastasis.Rab25 depletion blocked cell growth rate, inhibited colony formation, downregulated AKT phosphorylation, inhibited the Wnt signaling pathway and its target genes, and negatively regulated the invading ability of HCC cells. PMID: 26692100
- Rab25 expression is a potential prognostic index for advanced NSCLC patients and its inhibition may improve chemosensitization in NSCLC treatment. PMID: 26535714
- These results showed that high levels of Rab25 expression were significantly correlated with renal cell carcinoma invasion classification (P < 0.01), lymph-node metastasis (P < 0.001), and pathological stage (P < 0.01). PMID: 25686498
- High RAB25 expression is associated with good clinical outcome in patients with locally advanced head and neck squamous cell carcinoma. PMID: 24403269
- the crystal structure of Rab25 in complex with the C-terminal region of FIP2, which consists of a central dimeric FIP2 coiled-coil that mediates a heterotetrameric Rab25-(FIP2)2-Rab25 complex. PMID: 24056041
- Overexpression of Rab25 contributes to metastasis of bladder cancer through induction of epithelial-mesenchymal transition and activation of Akt/GSK-3beta/Snail signaling. PMID: 23722651
- These findings suggest that Rab25 plays an important role in tumor migration and metastasis, and that understanding its function may lead to the development of new strategies to prevent metastasis in oral cancer patients. PMID: 23340300
- Rab25 controls intestinal cell polarity through the regulation of gene expression PMID: 23345591
- RAB25 has been implicated in various cancers, with reports presenting it as both an oncogene and a tumour-suppressor gene. [Review] PMID: 23176489
- Studies using lentiviral-based overexpression and suppression systems lent support of Rab25 to function as an important tumor suppressor with both anti-invasive and -angiogenic abilities, through a deregulated FAK-Raf-MEK1/2-ERK signaling pathway. PMID: 22991305
- data showed Rab25 was highly expressed in all subtypes of epithelial ovarian cancers, and two subtypes of germ cell tumors, but not in sex cord stromal tumors; Rab25 expression was not correlated with peritoneal metastasis of ovarian cancer PMID: 23030522
- higher level of Rab25 was associated with lymphatic metastasis, specifically in ER and PR-positive breast cancer. PMID: 22644676
- Rab25 acts predominantly in the small-scale fast recycling within the tips of the cell. Our results further support the idea of Rab25 as a promoter of tumor development PMID: 22613965
- Rab25 induced the accumulation of glycogen in epithelial cancer cells, a process not previously identified. (RAB25) PMID: 22253197
- Rab25 effectively differentiates Mullerian carcinomas from malignant mesothelioma PMID: 22249560
- The present study delineates the fundamental elements of a core promoter structure that will be helpful for future studies regarding the regulation of RAB25 gene. PMID: 21075212
- Loss of Rab25 is associated with triple-negative breast cancer. PMID: 19795443
- Rab25 may function as a tumor suppressor in intestinal epithelial cells through regulation of protein trafficking to the cell surface. PMID: 20197623
- Rab25 signalling pathway plays a role in the regulation of cell proliferation and apoptosis in ovarian cancer cells, which indicates that the Rab25 gene plays a definite role in the development and aggressiveness of human ovarian cancer. PMID: 17393986
- Rab25 contributes to tumor progression by directing the localization of integrin-recycling vesicles and thereby enhancing the ability of tumor cells to invade the extracellular matrix. PMID: 17925226
顯示更多
收起更多
-
亞細胞定位:Cell membrane; Lipid-anchor; Cytoplasmic side. Cell projection, pseudopodium membrane. Cytoplasmic vesicle.
-
蛋白家族:Small GTPase superfamily, Rab family
-
組織特異性:Expressed in ovarian epithelium (NOE) and breast tissue. Expressed in ovarian cancer; expression is increased relative to NOE cells. Expression in ovarian cancer is stage dependent, with stage III and stage IV showing higher levels than early stage cancer
-
數據庫鏈接:
Most popular with customers
-
-
YWHAB Recombinant Monoclonal Antibody
Applications: ELISA, WB, IHC, IF, FC
Species Reactivity: Human, Mouse, Rat
-
Phospho-YAP1 (S127) Recombinant Monoclonal Antibody
Applications: ELISA, WB, IHC
Species Reactivity: Human
-
-
-
-
-